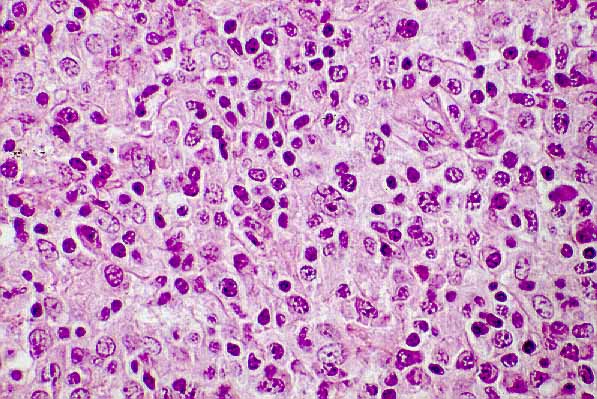
fig. 1

PROCESOS LINFOPROLIFERATIVOS (LINFOMAS Y ENFERMEDAD DE HODGKIN) EN ENFERMOS DE SIDA.
CARACTERIZACIÆN INMUNOMORFOLÆGICA
M Martin, MF Fresno, M Herreros, P Ablanedo, JM Garcia y A Herrero

ICONOGRAFëA
 |
|
Fig. 1. Hodgkin |
 |
|
Fig. 2. LMP-1 |
 |
|
Fig. 3. LIMB del SNC |
 |
|
Fig. 4. LMP-1 |
M Martin, MF Fresno, M Herreros, P Ablanedo, JM Garcia y A Herrero
Copyright ˋ 1998. Reservados todos los derechos.